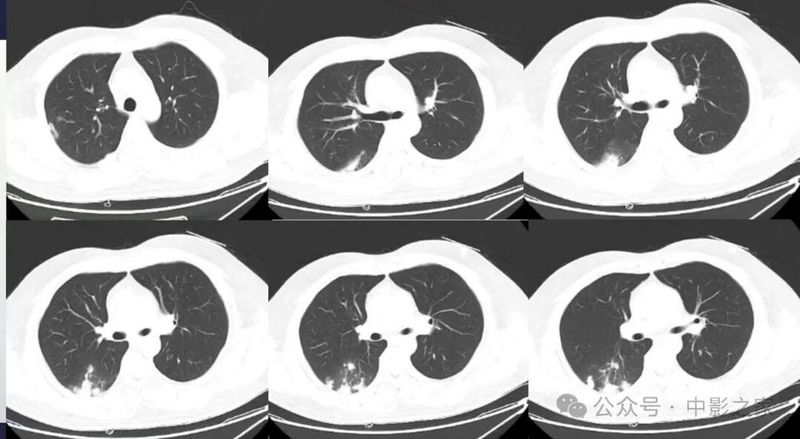
图片

概述
致病菌:新型隐球菌,格特隐球菌
感染途径:吸入含隐球菌的气溶胶
高危因素:潮湿环境或鸽粪
易感人群:免疫受损、免疫正常
感染部位:CNS、肺、皮肤等

病原学及发病机制
病原体为新型隐球菌

酵母菌属,具有黏液性荚膜

脑脊液印度墨汁染色,示多发荚膜酵母菌样结构
多存在于热带、亚热带区的土壤、朽木、鸽粪等中
中枢神经系统高亲和性,可播散至脑部引起隐球菌性脑膜炎

临床及实验室检查
1、症状缺乏特异性
体检发现肺部阴影,无明显症状
亚急性或慢性起病,低热、咳嗽等非特异性症状
2、实验室检查
白细胞计数正常或轻度升高.
血沉轻度升高
痰涂片、痰培养或血培养常为阴性
少数有血嗜酸性粒细胞升高
血清隐球菌英膜多糖抗原CrAg阳性
阳性率与免疫抑制状态、病变数目、大小有关,滴度与治疗效果有关
支气管肺泡灌洗液CrAg阳性
脑脊液墨汁染色阳性、脑脊液隐球菌 荚膜多糖抗原检测提示隐球菌性脑膜炎
病理

纤维化和慢性炎症的背景中见上皮样组织细胞、淋巴细胞、多核巨细胞等聚集形成肉芽肿,在单核细胞及多核巨细胞的胞质内可见吞噬的隐球菌菌体
菌体呈圆形或类圆形、大小不一(2~15um),常可见一层厚荚膜,周围形成透明的空隙

影像表现
影像学分型:
结节/肿块型
浸润实变型
弥漫粟粒型
混合型
一、结节肿块型
1、部位:一般位于胸膜下,背侧胸膜下为主,两下肺明显,上肺偏少(3/4位于下叶 )
肺泡巨噬细胞吞噬肺隐球菌后根植于肺循环末梢血流缓慢或停滞处的肺外周带。
2、与胸膜关系:2/3与胸膜之间有空隙,1/3与胸膜相连,表现为糊墙征(附近胸膜增厚、胸膜外脂肪间隙增宽)

3、大小:结节较小,多为2cm以下;
4、边缘:绝大部分边界清楚,边缘可见平直征、刀切征,可以有细小毛刺,比较纤细,多为晕征中毛刺,相对收缩力偏弱;少数病人收缩比较明显

5、密度及强化:实性部分密度均匀,约1/3内部可见空泡征、实变中的空洞或空腔(可以单个内壁光滑,也可以多分隔)、含气支气管征;增强后均匀强化(强化轻到中度)延迟强化;
6、与血管的关系:2/3近端与血管相连,部分血管自然穿过;

7、晕征:1/3有晕征,晕多范围较小,个别晕较大。

二、浸润实变型
1、分布多为下叶胸膜下
2、实变区密度均匀;
3、大部分病灶与胸膜相连(95%),糊墙征(个别可以栽赃)

4、晕征:大部分有,晕的大小不一致,相对而言实变区密度偏低的晕范围大一些,约20%无晕征;
5、实变区密度均匀或内部有片状低强化(各自占一半左右),且延迟强化;

6、实变区大部分边界清楚,有刀切征、平直征;20%边界稍模糊,30%周围有毛刺征;
7、含气支气管征与密度、晕征的关系:支气管可以直达远端,也可以近端堵塞,堵塞处支气管正常或稍扩张,走形正常;密度密实程度越高晕征越少,含气支气管近端堵塞的几率越高:如果周围晕征明显,密度偏低,边界欠清晰,含气支气管会直达远端;


8、空洞:约50%见到空洞或空腔,内壁光滑,可以多个组成,周围无坏死,内部无液平,可以有残余结构,个别内壁欠光滑;
9、近端均与血管相连。

三、弥漫粟粒型
粟粒性结节呈弥漫分布,此类型较为少见。


四、混合型
混合病变,分布于肺外带,表现为结节、肿块、半片、大叶实变多样化病灶共存。

